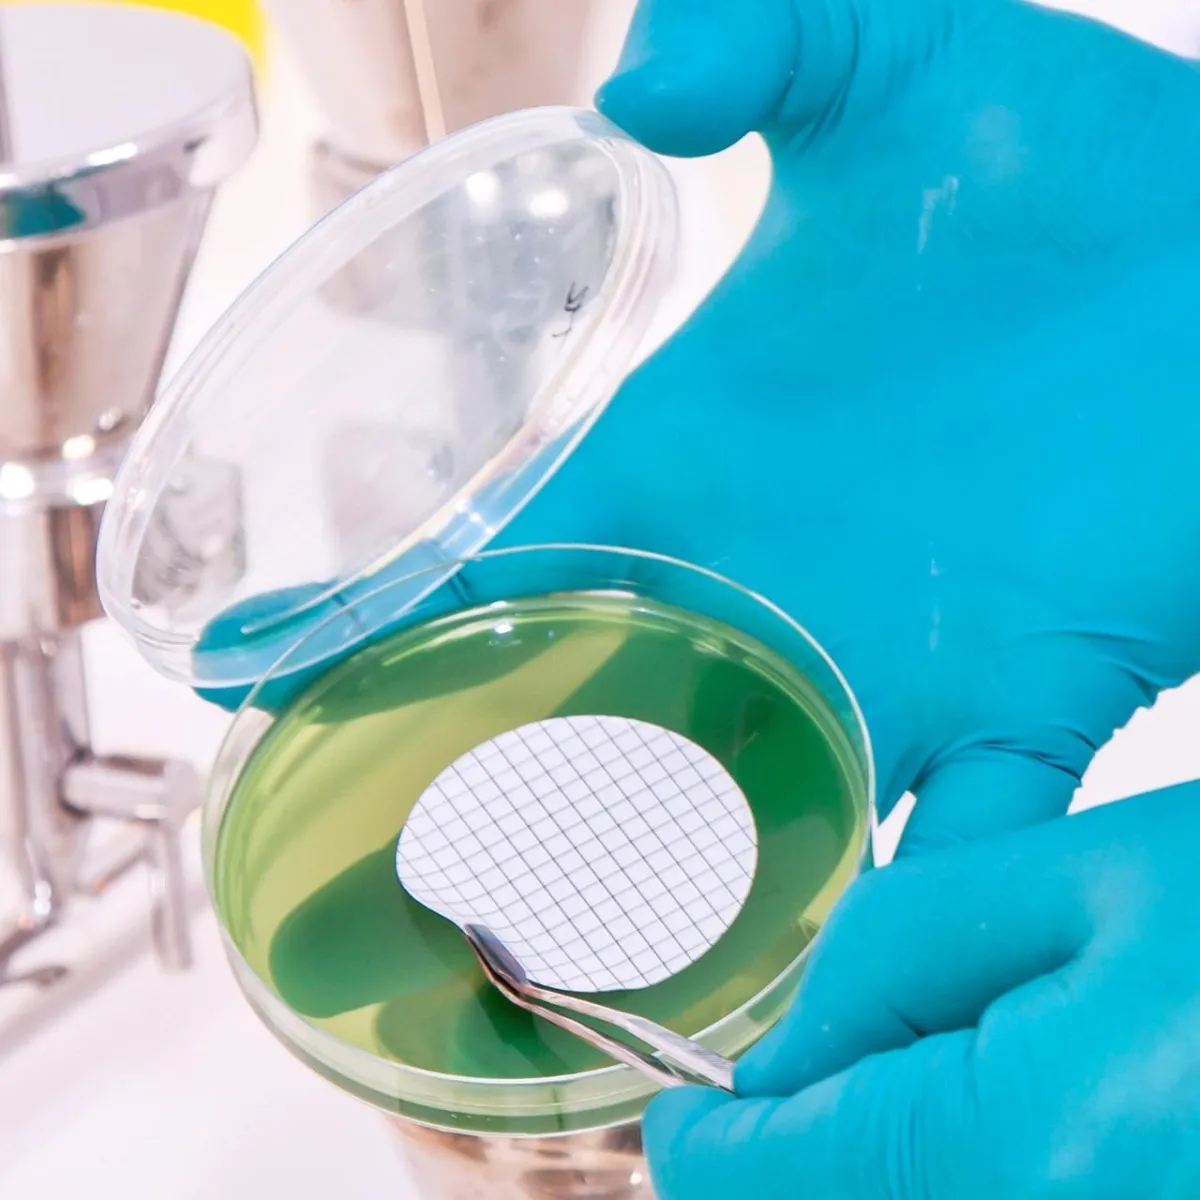
MCE Membrane Filters

MCE Membrane Filters
Products


Information
Nupore Mixed Cellulose Esters (MCE) membrane filters are composed of a mixture of cellulose nitrate and cellulose acetate polymers. These are hydrophilic membranes with excellent biocompatibility, superior flow rates, and high protein binding capacity.
Available in 0.45µ in both plain or gridded formats, these membranes are extensively used in microbiological analysis to support routine cell colony counting and particle detection.
